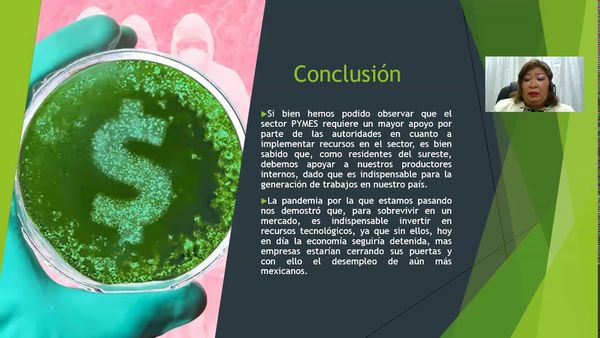
CCC-539 - INEQUIDAD TECNOLÓGICA, ADMINISTRATIVA Y TRIBUTARIA EN TIEMPOS DE PANDEMIA EN LAS PYMES U…

Celaya 2020 Congreso Virtual -- Ponencias Pre-Grabadas
CCC-528 - ESTADO DEL ARTE DE LA CONTABILIDAD AMBIENTAL PARA EL DESARROLLO SOSTENIBLE EN LAS PROVINC…
CCC-577 - CAPACIDAD DE LAS PLANTAS MEXICANAS DE MANUFACTURA AUTOMOTRIZ PARA IMPLEMENTAR EL CONCEPTO…